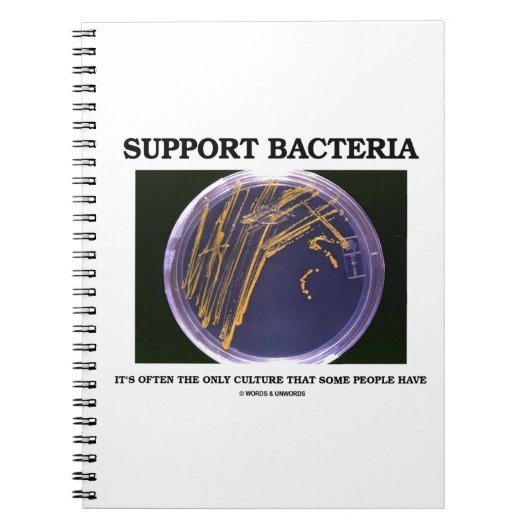

A propos de Carnets
Vendu (e) par
À propos de ce design
Carnet Support Bacteria
Il n'est pas nécessaire d'être bactériologue, microbiologiste ou biologiste pour profiter de ce dicton scientifique ironique qui comprend une plaque gélose avec des colonies bactériennes. Dire tout dit : "Soutenez les bactéries - C'est souvent la seule culture que certaines personnes ont". Faites faire un double tour avec n'importe quel de ces humours geeks à double sens qui disent des cadeaux sur le sujet de la culture !
Traduction automatique
Avis des clients
Aucun commentaires sur ce produit pour le momentAvez-vous acheté ce produit ?
Tags
Autres infos
Identifiant du produit : 130127446870757174
Fabriqué le 05/10/2015 13:48
Évalué G
Articles vus récemment